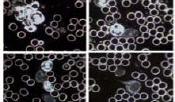

Sie sind hier: Startseite > Behandlungsspektrum
Die Naturheilkunde
beinhaltet ein Spektrum verschiedenster Methoden, um die körpereigenen
Fähigkeiten zur Selbstheilung ( Spontanheilung) zu aktivieren.
Dabei werden bevorzugt in der Natur vorkommende Mittel eingesetzt. Der
ganzheitliche Ansatz der unterschiedlichen Behandlungen ist, die oftmals
gestörte Harmonie des gesamten Organismus wieder ins Gleichgewicht zu
bringen. Dabei ist es wichtig nicht nur den Körper zu behandeln, sondern
auch Geist und Seele miteinzubeziehen.
Therapie & Behandlungsspektrum
| Akupunktur | Homöopathie | Bioresonanztherapie |
|
|
|
| Eigenblutbhandlung | Dorntherapie | Dunkelfelddiagnose |
|
|
|